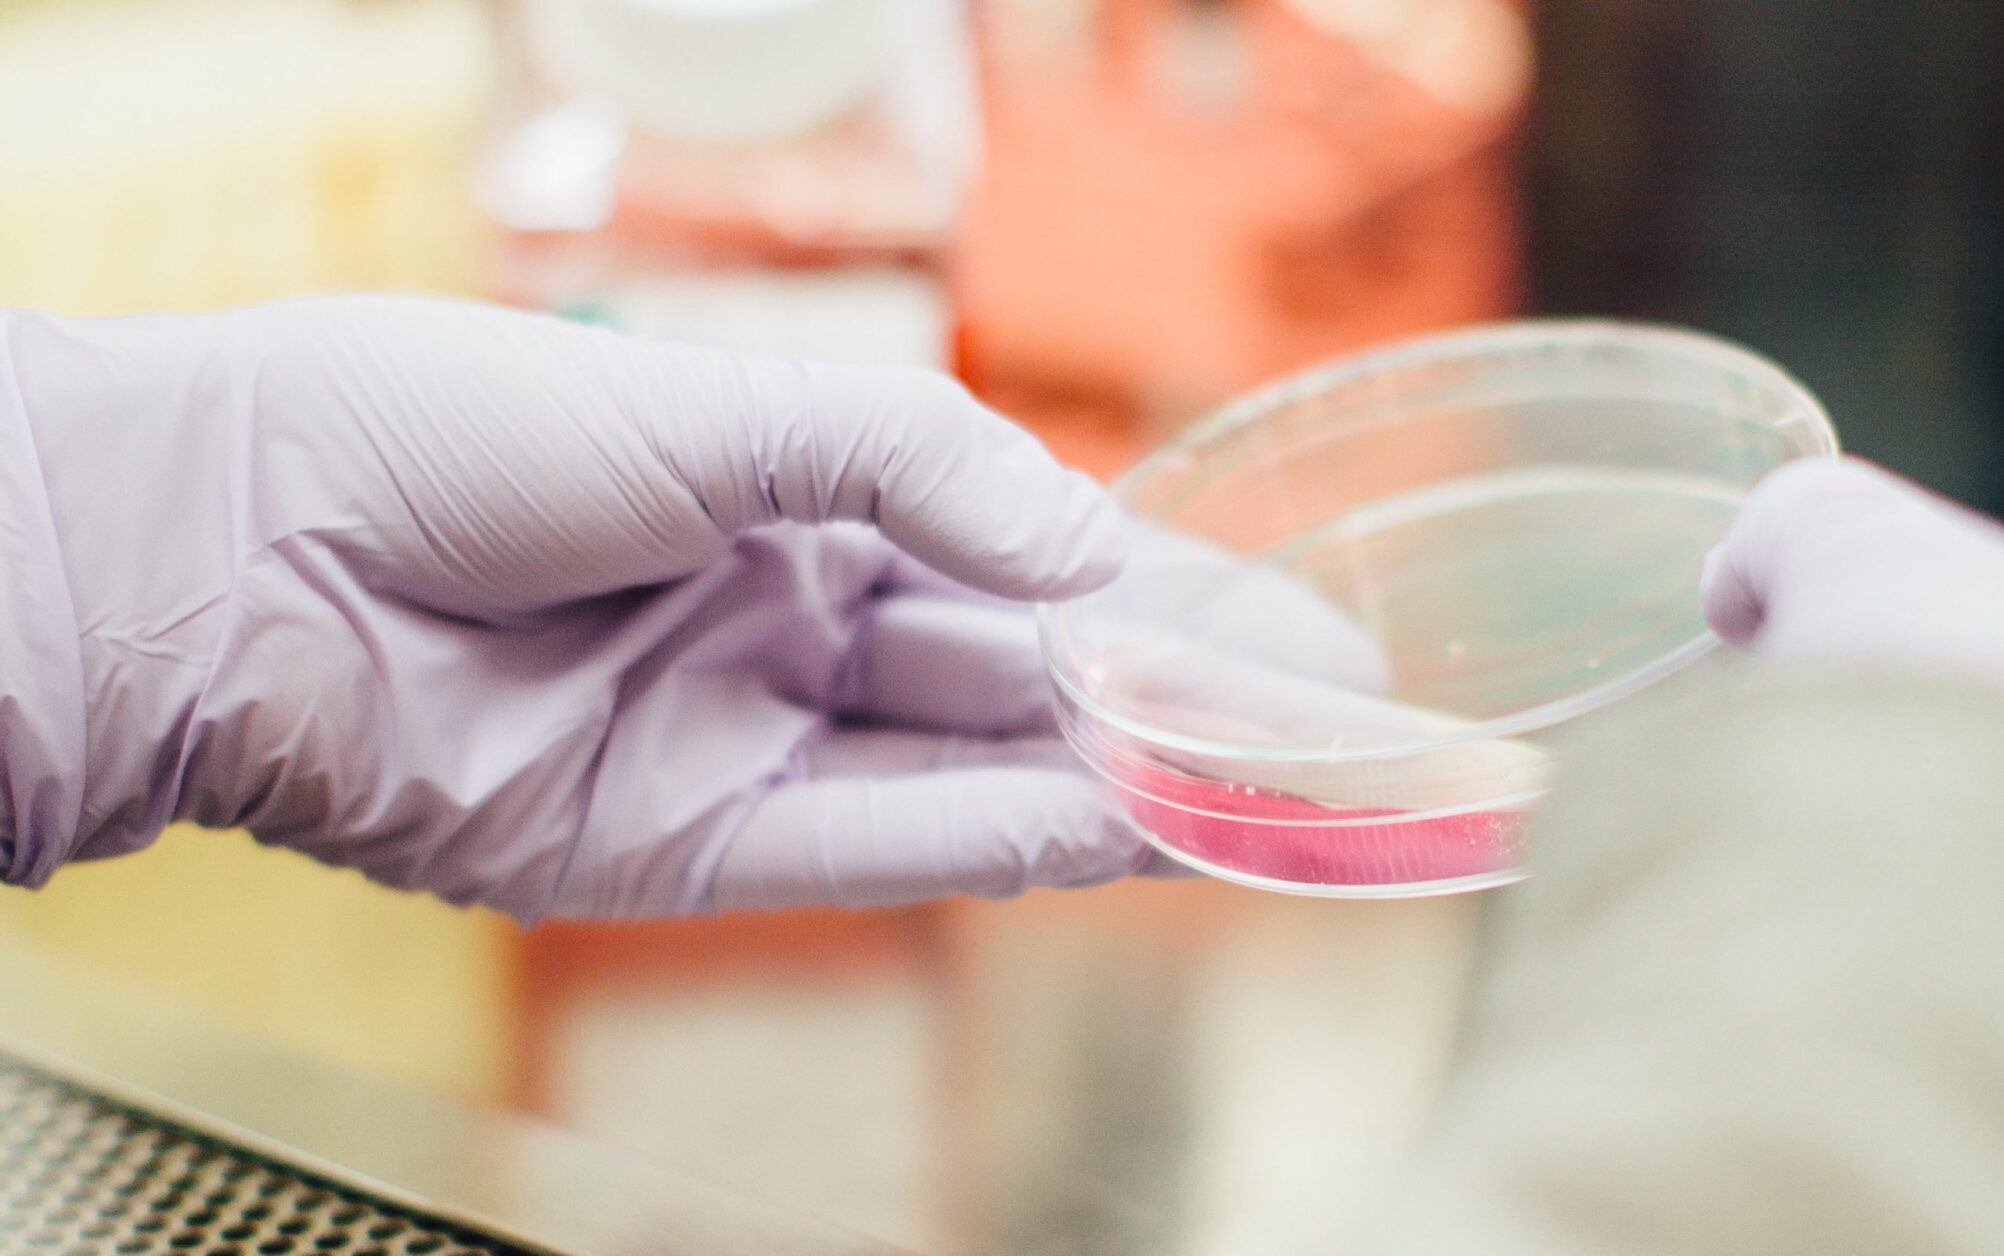
content-01-scaled-2004x1256 (1).jpg

UniSA Ventures is the technology translation, commercialisation, investment and intellectual property management company of the University of South Australia (UniSA).
UniSA Ventures is the technology translation, commercialisation, investment and intellectual property management company of the University of South Australia (UniSA).
By identifying research with solid commercial potential, and connecting with industry to license technology or create a spin-out company, we help UniSA’s researchers share their innovations with the world.

Unlocking the commercial potential of research requires expertise in both technology and business to bridge the gap between researchers, industry and investors.